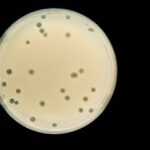

Aliados do presidente da Câmara, Hugo Motta (Republicanos-PB), dizem esperar um acordo com o presidente do Senado, Davi Alcolumbre (União Brasil-AP), acerca da tramitação das MPs (medidas provisórias) nas próximas semanas.
Eles afirmam que, com o acordo feito com o STF (Supremo Tribunal Federal) na semana passada para destravar o pagamento das emendas parlamentares, a tramitação das MPs será o próximo tema a ser discutido entre as cúpulas das duas Casas.
Segundo um deputado próximo de Motta, conversas sobre a questão já vêm ocorrendo entre os parlamentares. Ele diz que o que está na mesa hoje é retomar o rito constitucional, com a instalação de comissões mistas (formadas por deputados e senadores) para analisar as medidas enviadas pelo Executivo, com a relatoria distribuída alternadamente (ora um senador, ora um deputado federal).
Um outro aliado do presidente da Câmara diz que o restabelecimento das comissões mistas tem apoio entre os parlamentares porque pode dar protagonismo a deputados e senadores, que ganham visibilidade com a relatoria e presidência desses colegiados temporários.
Além disso, parlamentares governistas falam que há um compromisso de Motta de resolver esse impasse que foi discutido ainda na campanha do deputado à presidência da Câmara para ter o apoio do PT.
O rito constitucional que prevê a instalação das comissões mistas foi suspenso em março de 2020 em meio à redução de atividades no Congresso durante a pandemia da Covid-19. Nesse caso, elas eram votadas diretamente nos plenários das duas Casas, começando pela Câmara.
A tramitação dessas medidas virou uma crise entre o ex-presidente da Câmara Arthur Lira (PP-AL) e o ex-presidente do Senado Rodrigo Pacheco (PSD-MG), que divergiam sobre como se daria a análise dessas medidas.
Como resultado, poucas comissões mistas foram instaladas nos últimos dois anos, e o governo teve de enviar projetos de lei ao Congresso com teor semelhante às propostas para garantir que elas seriam apreciadas no Legislativo. Principal ferramenta legislativa do Executivo, as MPs tiveram o pior desempenho da historia nos dois primeiros anos da gestão Lula 3.
LINK PRESENTE: Gostou deste texto? Assinante pode liberar sete acessos gratuitos de qualquer link por dia. Basta clicar no F azul abaixo.

Deixe um comentário